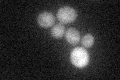
YJL121C
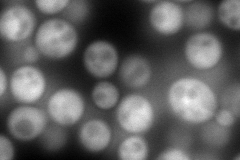
YJL121C
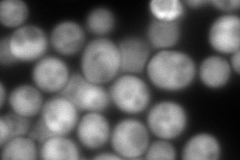
YJL121C
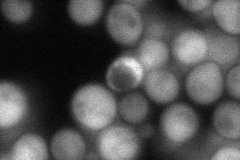
YJL121C
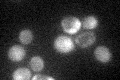
YJL121C

View description
D-ribulose-5-phosphate 3-epimerase, catalyzes a reaction in the non-oxidative part of the pentose-phosphate pathway; mutants are sensitive to oxidative stress
Localization:
Intensity:
Fold change:
Significance:
-
C’ GFP library in SD
cytosol33.32 -
N' NOP1pr-GFP in SD
cytosol343.689 -
N' TEF2pr-mCherry in SD
cytosol401.856 -
N' NATIVEpr-GFP in SD
cytosol88.8604 -
N' TEF2pr-VC and Cyto-VN in SD

#N/A0 -
C’ GFP library in SD+DTT

cytosol38.831.16No -
C’ GFP library in SD+H2O2

cytosol28.760.86No -
C’ GFP library in Starvation Media
cytosol39.111.17No -
C’ GFP library on the background of Pup2-DaMP

cytosol -
C’ GFP library on the background of CCT mutant

cytosol29.4670.884251No
